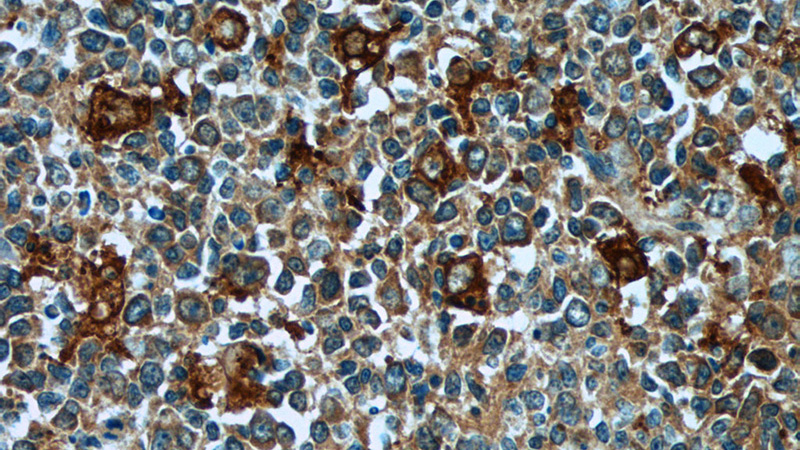
Immunohistochemistry of paraffin-embedded human tonsillitis tissue slide using Catalog No:109183(CEP63 Antibody) at dilution of 1:50 (under 40x lens)

-
Product Name
CEP63 antibody
- Documents
-
Description
CEP63 Rabbit Polyclonal antibody. Positive IHC detected in human tonsillitis tissue. Positive IF detected in HepG2 cells, MCF-7 cells. Positive WB detected in human placenta tissue, HEK-293 cells, HeLa cells, mouse liver tissue, mouse thymus tissue, PC-3 cells. Positive IP detected in HEK-293 cells. Observed molecular weight by Western-blot: 57-75kd
-
Tested applications
ELISA, WB, IF, IP, IHC
-
Species reactivity
Human,Mouse,Rat; other species not tested.
-
Alternative names
centrosomal protein 63kDa antibody; Centrosomal protein of 63 kDa antibody; CEP63 antibody; FLJ13386 antibody
-
Isotype
Rabbit IgG
-
Preparation
This antibody was obtained by immunization of CEP63 recombinant protein (Accession Number: XM_017007263). Purification method: Antigen affinity purified.
-
Clonality
Polyclonal
-
Formulation
PBS with 0.02% sodium azide and 50% glycerol pH 7.3.
-
Storage instructions
Store at -20℃. DO NOT ALIQUOT
-
Applications
Recommended Dilution:
WB: 1:500-1:5000
IP: 1:200-1:2000
IHC: 1:20-1:200
IF: 1:20-1:200
-
Validations

human placenta tissue were subjected to SDS PAGE followed by western blot with Catalog No:109183(CEP63 antibody) at dilution of 1:800

Immunofluorescent analysis of HepG2 cells, using CEP63 antibody Catalog No:109183 at 1:50 dilution and Rhodamine-labeled goat anti-rabbit IgG (red).

IP Result of anti-CEP63 (IP:Catalog No:109183, 3ug; Detection:Catalog No:109183 1:500) with HEK-293 cells lysate 1700ug.

Immunohistochemistry of paraffin-embedded human tonsillitis tissue slide using Catalog No:109183(CEP63 Antibody) at dilution of 1:50 (under 10x lens)
Immunohistochemistry of paraffin-embedded human tonsillitis tissue slide using Catalog No:109183(CEP63 Antibody) at dilution of 1:50 (under 40x lens)
-
Background
CEP63 is a 63 kDa centrosomal protein. It is required for normal spindle assembly. It maintains centrosome numbers through centrosomal recruitment of CEP152. CEP63 recruits CDK1 to centrosomes. It plays a role in DNA damage response. This antibody can recognize all the four isoforms of CEP63 (56 kDa, 58 kDa, 63 kDa and 81 kDa).
-
References
- Brown NJ, Marjanović M, Lüders J, Stracker TH, Costanzo V. Cep63 and cep152 cooperate to ensure centriole duplication. PloS one. 8(7):e69986. 2013.
- Zhao Z, Oh S, Li D. A dual role for UVRAG in maintaining chromosomal stability independent of autophagy. Developmental cell. 22(5):1001-16. 2012.
- Kodani A, Yu TW, Johnson JR. Centriolar satellites assemble centrosomal microcephaly proteins to recruit CDK2 and promote centriole duplication. eLife. 4:. 2015.
- He S, Zhao Z, Yang Y. Truncating mutation in the autophagy gene UVRAG confers oncogenic properties and chemosensitivity in colorectal cancers. Nature communications. 6:7839. 2015.
Related Products / Services
Please note: All products are "FOR RESEARCH USE ONLY AND ARE NOT INTENDED FOR DIAGNOSTIC OR THERAPEUTIC USE"
